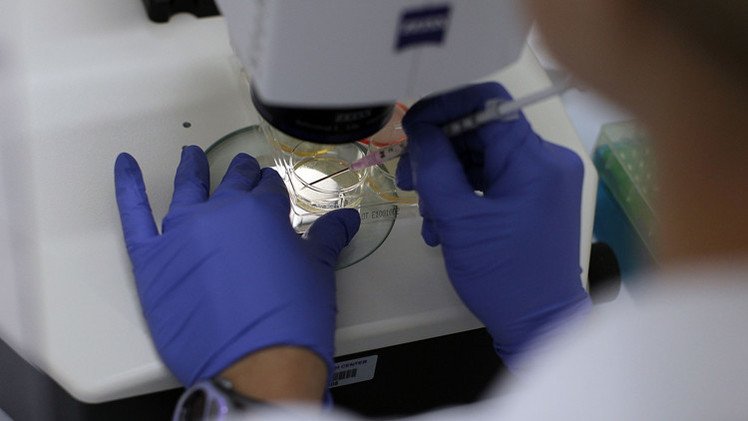
لأول مرة...العلماء ينتجون خلية جنسية بشرية أولية

Stories
-
![مونديال 2026]()
مونديال 2026
RT STORIES
كيف تحسم بطاقات التأهل إلى دور الـ32 في كأس العالم 2026؟
![كيف تحسم بطاقات التأهل إلى دور الـ32 في كأس العالم 2026؟]() #اسأل_أكثر #Question_More
#اسأل_أكثر #Question_MoreRT STORIES
منتخب السنغال يتلقى ضربة مؤثرة قبل مواجهة العراق
![منتخب السنغال يتلقى ضربة مؤثرة قبل مواجهة العراق]() #اسأل_أكثر #Question_More
#اسأل_أكثر #Question_MoreRT STORIES
مشجع الكونغو الشهير يظهر لأول مرة في كأس العالم 2026
![مشجع الكونغو الشهير يظهر لأول مرة في كأس العالم 2026]() #اسأل_أكثر #Question_More
#اسأل_أكثر #Question_MoreRT STORIES
الأرجنتين تستعد لاحتفال غير تقليدي بعيد ميلاد ميسي الـ39
![الأرجنتين تستعد لاحتفال غير تقليدي بعيد ميلاد ميسي الـ39]() #اسأل_أكثر #Question_More
#اسأل_أكثر #Question_MoreRT STORIES
جدل المليارات يلاحق مونديال 2026.. و"فيفا" تكشف حقيقة العوائد الإعلانية
![جدل المليارات يلاحق مونديال 2026.. و"فيفا" تكشف حقيقة العوائد الإعلانية]() #اسأل_أكثر #Question_More
#اسأل_أكثر #Question_MoreRT STORIES
مدرب غانا بعد التعادل مع نجلترا: "حكم الـVAR ذهبت لشرب القهوة!"
![مدرب غانا بعد التعادل مع نجلترا: "حكم الـVAR ذهبت لشرب القهوة!"]() #اسأل_أكثر #Question_More
#اسأل_أكثر #Question_MoreRT STORIES
الجولة الثالثة في كأس العالم 2026… "أسبوع الحسم" للمنتخبات العربية
![الجولة الثالثة في كأس العالم 2026… "أسبوع الحسم" للمنتخبات العربية]() #اسأل_أكثر #Question_More
#اسأل_أكثر #Question_MoreRT STORIES
بعد نهاية الجولة الثانية من مونديال 2026.. ماهي المنتخبات المتأهلة لدو الـ32 حتى الآن؟!
![بعد نهاية الجولة الثانية من مونديال 2026.. ماهي المنتخبات المتأهلة لدو الـ32 حتى الآن؟!]() #اسأل_أكثر #Question_More
#اسأل_أكثر #Question_MoreRT STORIES
مونيوز يقود كولومبيا لتأهل مستحق إلى دور الـ32 من مونديال 2026
![مونيوز يقود كولومبيا لتأهل مستحق إلى دور الـ32 من مونديال 2026]() #اسأل_أكثر #Question_More
#اسأل_أكثر #Question_MoreRT STORIES
أسطورة إيطاليا كانافارو يفاجئ الجميع بطلب مثير لرونالدو بعد خماسية البرتغال
![أسطورة إيطاليا كانافارو يفاجئ الجميع بطلب مثير لرونالدو بعد خماسية البرتغال]() #اسأل_أكثر #Question_More
#اسأل_أكثر #Question_MoreRT STORIES
كرواتيا تنعش آمالها وتقصي بنما من كأس العالم 2026
![كرواتيا تنعش آمالها وتقصي بنما من كأس العالم 2026]() #اسأل_أكثر #Question_More
#اسأل_أكثر #Question_MoreRT STORIES
نبض اليوم الـ14 من المونديال.. حسم بطاقات العبور ومواجهات لا تقبل القسمة على اثنين
![نبض اليوم الـ14 من المونديال.. حسم بطاقات العبور ومواجهات لا تقبل القسمة على اثنين]() #اسأل_أكثر #Question_More
#اسأل_أكثر #Question_More![مونديال 2026]() مونديال 2026
مونديال 2026
-
![اتفاق أمريكي إيراني لوقف الحرب على جميع الجبهات]()
اتفاق أمريكي إيراني لوقف الحرب على جميع الجبهات
RT STORIES
ترامب يهدد بوقف المفاوضات مع إيران
![ترامب يهدد بوقف المفاوضات مع إيران]() #اسأل_أكثر #Question_More
#اسأل_أكثر #Question_MoreRT STORIES
ترامب: نغادر إيران الآن وهي دون قدرات صاروخية أو برنامج نووي
![ترامب: نغادر إيران الآن وهي دون قدرات صاروخية أو برنامج نووي]() #اسأل_أكثر #Question_More
#اسأل_أكثر #Question_MoreRT STORIES
شهباز شريف: برنامج الصواريخ الباليستية الإيراني لم يكن مطروحا في التفاهمات مع واشنطن
![شهباز شريف: برنامج الصواريخ الباليستية الإيراني لم يكن مطروحا في التفاهمات مع واشنطن]() #اسأل_أكثر #Question_More
#اسأل_أكثر #Question_More![اتفاق أمريكي إيراني لوقف الحرب على جميع الجبهات]() اتفاق أمريكي إيراني لوقف الحرب على جميع الجبهات
اتفاق أمريكي إيراني لوقف الحرب على جميع الجبهات
-
العملية العسكرية الروسية في أوكرانيا
RT STORIES
قنابل حائمة تستهدف مواقع القوات الأوكرانية
#اسأل_أكثر #Question_MoreRT STORIES
الدفاع الروسية تعلن تحرير بلدة جديدة شمال أوكرانيا
![الدفاع الروسية تعلن تحرير بلدة جديدة شمال أوكرانيا]() #اسأل_أكثر #Question_More
#اسأل_أكثر #Question_MoreRT STORIES
مقاطعة زابوروجيه.. طائرات مسيرة من طراز "غيران" الروسية تستهدف محطة فرعية لتوزيع الغاز الأوكراني
#اسأل_أكثر #Question_MoreRT STORIES
لافروف: منفتحون على التفاوض حول أوكرانيا ونحذر من أي خطط توسعية بمنطقة المصالح الحيوية الروسية
![لافروف: منفتحون على التفاوض حول أوكرانيا ونحذر من أي خطط توسعية بمنطقة المصالح الحيوية الروسية]() #اسأل_أكثر #Question_More
#اسأل_أكثر #Question_MoreRT STORIES
روسيا.. مقتل شخص وإصابة آخر بهجوم مسيرة أوكرانية
![روسيا.. مقتل شخص وإصابة آخر بهجوم مسيرة أوكرانية]() #اسأل_أكثر #Question_More
#اسأل_أكثر #Question_MoreRT STORIES
الخارجية الأوكرانية: زيلينسكي لن يتوجه إلى بولندا لتجنب فضائح
![الخارجية الأوكرانية: زيلينسكي لن يتوجه إلى بولندا لتجنب فضائح]() #اسأل_أكثر #Question_More
#اسأل_أكثر #Question_MoreRT STORIES
توسك: مؤتمر أوكرانيا سيكون أكثر جدوى بدون زيلينسكي
![توسك: مؤتمر أوكرانيا سيكون أكثر جدوى بدون زيلينسكي]() #اسأل_أكثر #Question_More
#اسأل_أكثر #Question_MoreRT STORIES
ريابكوف: مواجهة مباشرة مع الغرب ستقود إلى عواقب كارثية وروسيا ستتخذ إجراءات مضادة في بحر البلطيق
![ريابكوف: مواجهة مباشرة مع الغرب ستقود إلى عواقب كارثية وروسيا ستتخذ إجراءات مضادة في بحر البلطيق]() #اسأل_أكثر #Question_More
#اسأل_أكثر #Question_Moreالعملية العسكرية الروسية في أوكرانيا
-
فيديوهات
RT STORIES
الولايات المتحدة.. رياح عاتية تلحق أضرارا واسعة في ولاية إنديانا
#اسأل_أكثر #Question_MoreRT STORIES
الصين.. شركة "ديب روبوتيكس" الصينية تكشف عن كلب آلي لمكافحة الحرائق
#اسأل_أكثر #Question_Moreفيديوهات
-
![رونالدينيو يعود إلى الملاعب بعمر 46 عاما عبر بوابة فريق إيطالي]()
رونالدينيو يعود إلى الملاعب بعمر 46 عاما عبر بوابة فريق إيطالي
RT STORIES
رونالدينيو يعود إلى الملاعب بعمر 46 عاما عبر بوابة فريق إيطالي
![رونالدينيو يعود إلى الملاعب بعمر 46 عاما عبر بوابة فريق إيطالي]() #اسأل_أكثر #Question_More
#اسأل_أكثر #Question_More
لأول مرة...العلماء ينتجون خلية جنسية بشرية أولية
تمكن العلماء لأول مرة في التاريخ من انتاج خلية جنسية بشرية أولية "primary germ cell" من الخلايا الجذعية للإنسان.
تألف الفريق العلمي الذي انتج هذه الخلية من علماء جامعة كمبردج البريطانية ومعهد وايزمان الاسرائيلي. ويقول البروفيسور ناوكو ايري، ان الخلية الجنسية الأولية، هي إحدى المراحل الأولية لنشوء الجنين.
ويذكر ان العلماء تمكنوا من انتاج خلايا جنسية أولية من الخلايا الجذعية للقوارض المخبرية، ولكن لم يسبق اجراء مثل هذه التجارب على الخلايا البشرية.
ويشير العلماء الى انهم لم يستخدموا الجين SOX17، الذي يلعب في جسم الإنسان دورا مهما جدا، لم يستخدموه في انتاج الخلية الجنسية الأولية للقوارض المخبرية. وأكثر من هذا، تمكن الباحثون من اثبات إمكانية انتاج الخلية الجنسية الأولية باستخدام خلايا جذعية طبيعية، وباستخدام خلايا جلدية أعيدت "برمجتها" الى خلايا جذعية.
المصدر: RT+ غازيتا.رو




































































































































التعليقات